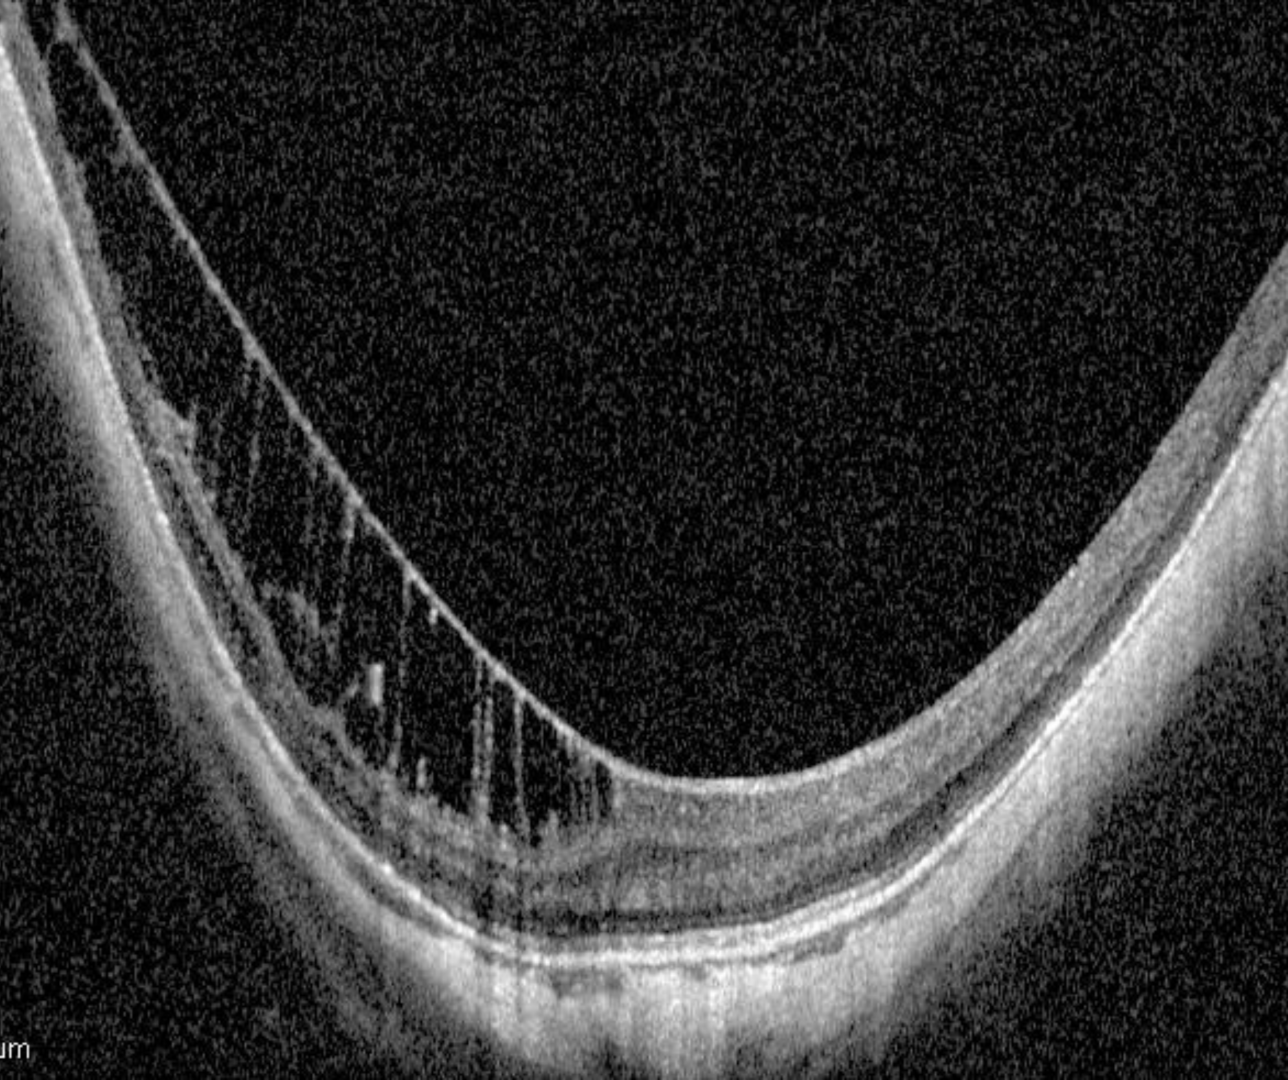

Overview
Inner limiting membrane (ILM) detachments are thought to result from staphyloma related traction in combination with the rigidity of the inner limiting membrane. They are often associated with an underlying retinoschisis in high myopes and may progress over time.
On OCT the inner-most retinal layer (the ILM) detaches from the rest of the retinal layers. There is often residual tissue that bridges the membrane to the retinal tissue and this can help differentiate an ILM detachment from an ERM. The bridges may be lost however with time, increased traction and retinal atrophy.
Case Examples
Differential diagnosis
References
Ng, D., Cheung, C., Luk, F. et al. (2016) Advances of optical coherence tomography in myopia and pathologic myopia. Eye 30, 901–916
Yasushi, I. (2017) Overview of the complications of high myopia, Retina: Volume 37 - Issue 12 - p 2347-2351


